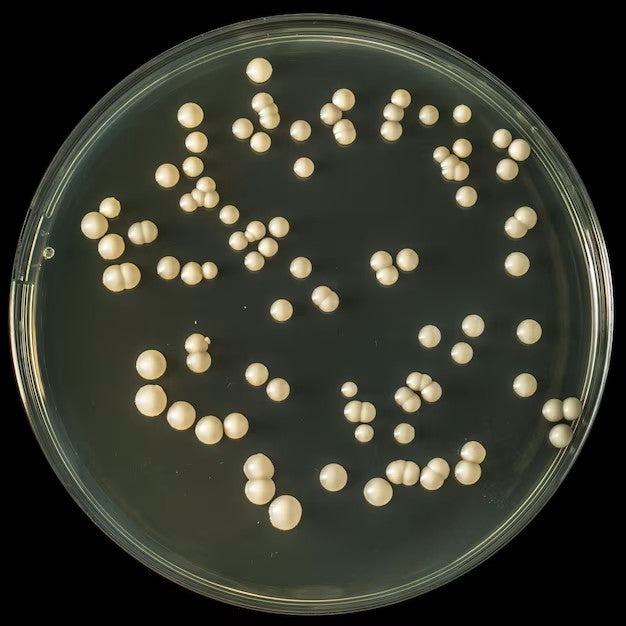

Mouse Quick-genotyping DNA Preparation Kit
A simplified system to get tail, ear punch or toe DNA ready for PCR in 30 minutes. The DNA preparation is good for routine PCR genotyping. No organic solvent involved and no extra proteinase K needed.
Zebra Fish Quick-genotyping DNA Preparation Kit
A simplified system to get any Zebra fish tissue DNA ready for PCR in 30 minutes. No organic solvent involved no extra proteinase needed.
Yeast Quick-genotyping DNA Preparation Kit
A simplified system to get yeast DNA ready for direct PCR in 30 minutes. No organic solvent involved no extra proteinase needed.